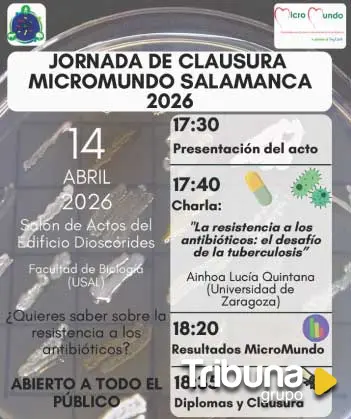

El objetivo es centralizar recursos y ofrecer una atención personalizada para garantizar la igualdad de oportunidades en unas pruebas que este año no tendrá apenas cambios
Salamanca clausura el proyecto MicroMundo con los últimos avances contra la resistencia bacteriana
El edificio Dioscórides acoge este martes una conferencia sobre el impacto de los antibióticos en la tuberculosis y la presentación de resultados de la edición 2026
El proyecto MicroMundo celebra este martes, 14 de abril, su jornada de clausura
en Salamanca con una conferencia abierta al público centrada en uno de los retos científicos y sanitarios más urgentes: la resistencia a los antibióticos y su impacto en enfermedades como la tuberculosis.
El evento, coordinado desde el Instituto de Biología Funcional y Genómica (IBFG, CSIC-USAL), tendrá lugar a las 17:30 horas en el salón de actos del edificio Dioscórides de la Facultad de Biología. Durante la jornada se presentarán también los resultados obtenidos en Salamanca en la edición 2026 del proyecto.
La conferencia principal será impartida por Ainhoa Lucía Quintana, investigadora de la
Universidad de Zaragoza, quien explicará cómo la resistencia a los antimicrobianos se ha convertido en una amenaza creciente para la salud pública.
La experta abordará especialmente el caso de la tuberculosis, una enfermedad tratable con antibióticos cuya eficacia terapéutica se ve cada vez más comprometida por la aparición de bacterias resistentes.
La resistencia a los antimicrobianos es un fenómeno complejo que afecta a humanos, animales y medioambiente. El uso de estos compuestos en medicina, ganadería y agricultura favorece la aparición de bacterias resistentes que pueden propagarse entre especies y a través del entorno.
Este escenario pone de relieve la necesidad de abordar el problema desde una perspectiva de Salud Global, entendiendo que la salud humana, animal y ambiental están estrechamente interconectadas.
Según estudios internacionales, en 2019 se registraron 1,27 millones de muertes
directamente asociadas a infecciones por bacterias resistentes, cifra que asciende a 4,95 millones si se consideran también sus efectos indirectos. En España, el Plan Nacional de Resistencia a Antibióticos trabaja desde 2014 para frenar este problema mediante estrategias centradas en la investigación, la vigilancia y la
concienciación social.
En este contexto, MicroMundo se consolida como una iniciativa clave que combina investigación científica y aprendizaje-servicio. Su objetivo es descubrir microorganismos productores de nuevos antibióticos, al tiempo que sensibiliza a la población sobre el uso responsable de estos fármacos.
En su novena edición en Salamanca han participado 25 estudiantes universitarios y 92 alumnos de centros educativos salmantinos __EMDASH__IES Fray Luis de León, Colegio María Auxiliadora, IES Senara (Babilafuente) y Colegio Santa Teresa de Jesús__EMDASH__ junto con jóvenes de la asociación YMCA.
La edición 2026 ha sido financiada por la Unidad de Aprendizaje y Servicio de la Universidad de Salamanca y cuenta con la colaboración de la Unidad de Cultura Científica y de la Innovación y la Facultad de Biología.
El plazo de matrícula se abre este lunes, 18 de mayo, para la convocatoria ordinaria, que tendrá lugar la primera semana de junio
La institución salmantina participa en Lituania en un encuentro clave del proyecto internacional ReNature, cofinanciado por el programa Erasmus+
La titulación ha recibido ya el informe definitivo favorable de la Agencia para la Calidad del Sistema Universitario de Castilla y León























